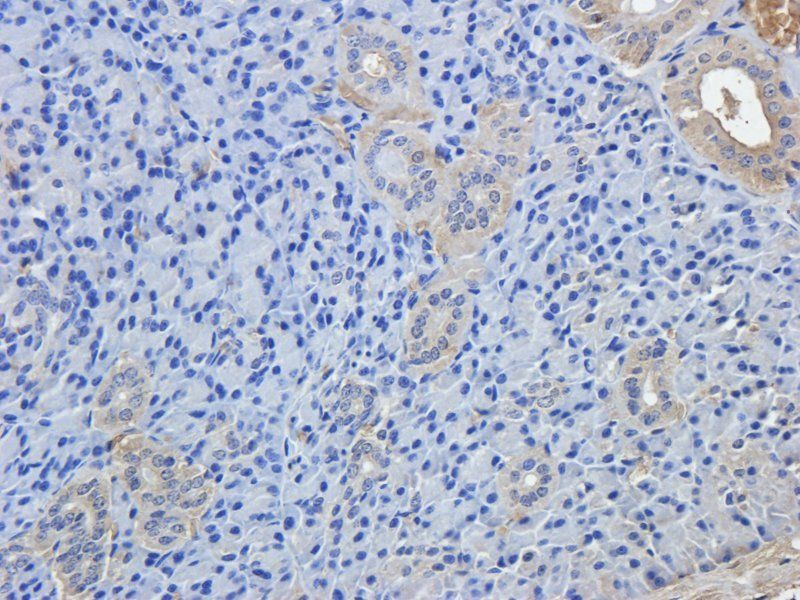
产品细节图片3

相关产品推荐更多 >
万千商家帮你免费找货
0 人在求购买到急需产品
- 详细信息
- 文献和实验
- 技术资料
- 抗体名:
BCL2 antibody抗体
- 抗体英文名:
BCL2 antibody
- 靶点:
BCL2
- 浓度:
- 100 μg (in 200 μl): 0.5 mg/ml- 200 μg (in 400 μl): 0.5 mg/ml
- 应用范围:
ELISA, ICC, IF, IHC-P, WB
- 宿主:
Rabbit
- 保质期:
6-12个月
- 抗原来源:
详询
- 目录编号:
orb10173
- 级别:
科研级
- 库存:
88
- 供应商:
biorbyt
- 标记物:
Unconjugated
- 克隆性:
Polyclonal
- 形态:
10 mM PBS, 0.02% sodium azide
- 亚型:
IgG
- 免疫原:
KLH conjugated synthetic peptide derived from human BCL2. Please contact us for the exact immunogen sequence. The peptide is available as orb374703.
- 规格:
100 ug
别名:anti-Apoptosis regulator Bcl 2 antibody, anti- Apoptosis regulator BCL2 antibody, anti- Apoptosis regulator BCL2 antibody, anti- AW986256 antibody, anti- B cell CLL/lymphoma 2 antibody, anti- B cell leukemia/lymphoma 2 antibody, anti- BCL2 antibody, anti- BCL2 antibody, anti- BCL2_human antibody, anti- C430015F12Rik antibody, anti- D630044D05Rik antibody, anti- D830018M01Rik antibody, anti- Leukemia/lymphoma, B-cell, 2 antibody, anti- Oncogene B-cell leukemia 2 antibody, anti- PPP1R50 antibody, anti- Protein phosphatase 1, regulatory subunit 50 antibody
免疫原:KLH conjugated synthetic peptide derived from human BCL2. Please contact us for the exact 免疫原 sequence. The peptide is available as orb374703.
分子量:26 kDa
应用稀释比例:WB: 1:100-1000, IHC-P: 1:100-500, IF/ICC: 1:100-600 (based on 0.5mg/ml)
纯度:Polyclonal antibodies are purified by peptide affinity chromatography
保存说明:Maintain refrigerated at 2-8°C for up to 2 weeks. For long term storage store at -20°C in small aliquots to prevent freeze-thaw cycles.
Pubmed:33510839, 38100948, 39994295, 40562117, 32901872
NCBI:000624, 21, 000633
Entrez:596
UniProt ID:P49950, P10417, P10415
Note:For research use only.

风险提示:丁香通仅作为第三方平台,为商家信息发布提供平台空间。用户咨询产品时请注意保护个人信息及财产安全,合理判断,谨慎选购商品,商家和用户对交易行为负责。对于医疗器械类产品,请先查证核实企业经营资质和医疗器械产品注册证情况。
 文献和实验
文献和实验heartknot2001 向经常看文章的站友们问一个问题。 针对Bcl2的抗凋亡作用,谁看过其上游是否有什么转录调控因子可以控制Bcl2表达的文章?或者是有,但是文章并没有充分证明,仅仅是提示可能而已?还是它不受调控呢? 能回答的详细些吗?或者你手头就有这样的文章,能发给我看一下吗? 我的邮箱:heartknot2001@yahoo.com.cn 谢谢你的帮助 freecell http
元元上回用 targetscan 和 starbase 告诉大家查找 miRNA 结合位点,如何用数据库查找 miRNA 结合位点(今天学的是寻找基因的 3’UTR 和 miRNA 的碱基序列,最终预测 miRNA 与目标 mRNA 在 3’UTR 的结合位点)例如咱们在 starbase 看到如下结果:划红线的结果是 miR34A-5P 与 BCL2 存在结合位点,有三个数据库预测到这种关系。现在咱们用 RNA22Sites 这个网站也来寻找 miRNA 结合位点。进入这个网站:https
手把手教你如何用数据库查找 miRNA 结合位点 | 实验时间
元元上回用 targetscan 和 starbase 告诉大家查找 miRNA 结合位点,如何用数据库查找 miRNA 结合位点(今天学的是寻找基因的 3’UTR 和 miRNA 的碱基序列,最终预测 miRNA 与目标 mRNA 在 3’UTR 的结合位点)例如咱们在 starbase 看到如下结果:划红线的结果是 miR34A-5P 与 BCL2 存在结合位点,有三个数据库预测到这种关系。现在咱们用 RNA22Sites 这个网站也来寻找 miRNA 结合位点。进入这个网站:https
 技术资料
技术资料暂无技术资料 索取技术资料











